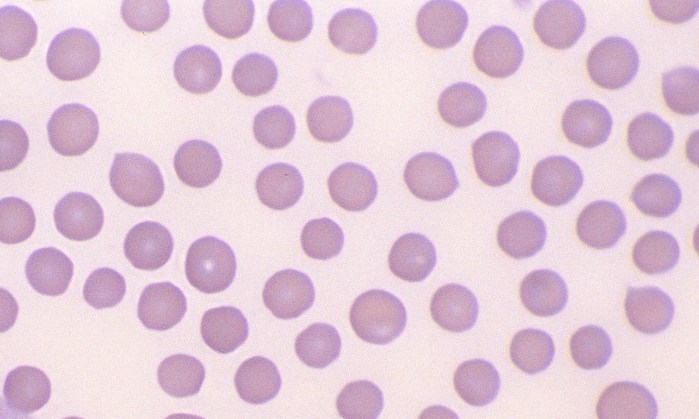
Normal Bovine 3

Normal Bovine Erythrocytes
Morphology: relatively small red blood cells with mild anisocytosis and a small amount of central pallor.
Lifespan: 160 days
Other features: basophilic stippling common with regenerative response. Young calves (< 3 months) may show marked poikilocytosis, thrombocytosis, and microcytosis (microcytosis may persist up to 1 year of age due to physiologic iron deficiency). Polychromatophils are rare in healthy cattle.



